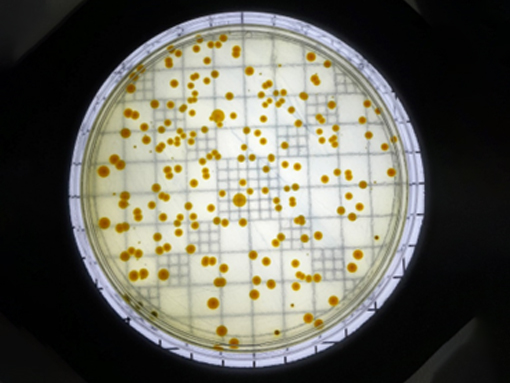
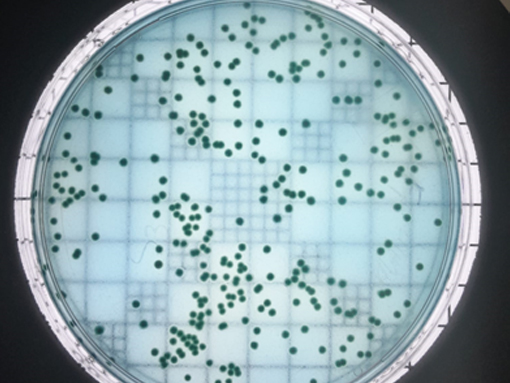

-
Strict Quality Practices
-
New Advanced Instruments
-
Customized Lab Solutions
About Precise Aqua Lab
Welcome to Precise Aqua Lab, a trusted leader in aquatic animal health and environmental diagnostics, established on October 2, 2023. We specialize in providing comprehensive disease diagnosis for a wide range of aquatic species, including shrimps (Penaeus vannamei, Penaeus monodon, Fishes and crabs. Our goal is to ensure the health and well-being of your aquatic livestock through accurate and timely diagnostics.
Our PCR Kits
Our high-quality PCR and qPCR kits are designed specifically for the aquaculture industry, enabling rapid and accurate pathogen detection. With advanced technology and strict quality control, our kits enhance biosecurity and support effective disease management, helping ensure the health and sustainability of your aquatic stock for optimal operational success.
Get EnquiryPRECISE AQUA LAB
Our Services
Our Services
PRECISE AQUA LAB
Enterocytozoon hepatopenaei (EHP) is a microsporidian parasite that infects the hepatopancreas of shrimp, particularly Penaeus vannamei and Penaeus monodon. It causes stunted growth and poor feed conversion without significant mortality, affecting shrimp aquaculture globally. EHP is transmitted orally through contaminated water or infected shrimp and can persist in pond environments, leading to chronic infections.
Contact Now
Our Services
PRECISE AQUA LAB
White Spot Syndrome Virus (WSSV) is a highly contagious virus that causes rapid death, lethargy, and high mortality rates, often leading to mass die-offs within a few days of infection in shrimp, marked by white spots on the exoskeleton. It spreads quickly in aquaculture where prevention through strict biosecurity measures and the use of virus-free broodstock is essential
Contact Now
Our Services
PRECISE AQUA LAB
Infectious Hypodermal and Hematopoietic Necrosis Virus (IHHNV) is a virus that infects shrimp, causing deformities, slow growth, and reduced survival, especially in Penaeus vannamei and Penaeus stylirostris. It spreads easily in aquaculture, but infected shrimp often survive with growth issues. Biosecurity measures help control its spread.
Contact Now
Our Services
PRECISE AQUA LAB
Infectious Myonecrosis Virus (IMNV) is a viral pathogen that primarily affects Penaeus vannamei (white leg shrimp), causing muscle necrosis, pale or white muscle, reduced mobility, and high mortality, especially during environmental stress. It spreads easily in shrimp farms via infected animals and contaminated water. No specific treatment exists, so strict biosecurity and management practices are essential for prevention.
Contact Now
Our Services
PRECISE AQUA LAB
Vibrio is a genus of bacteria commonly found in marine and estuarine environments affects aquatic animals, particularly fish and shrimp, causing symptoms like lesions, hemorrhages, and mortality. It spreads in poor water quality and overcrowded conditions. Vibrio infections are managed through biosecurity, probiotics, and proper water quality control.
Contact Now
Our Services
PRECISE AQUA LAB
At our water quality testing services, we offer comprehensive analysis of various water parameters to ensure safety and environmental compliance. Our tests cover key indicators such as pH, dissolved oxygen (DO), Ammonia, Alkalinity, EC, Total Hardness, Sodium, Potassium and total dissolved solids (TDS).
Contact Now
Our Services
PRECISE AQUA LAB
Our soil analysis lab offers comprehensive testing of key parameters including pH, nutrient levels (Ca, P, K), organic matter and soil texture. We provide insights to optimize soil health for aquaculture and environmental management, ensuring sustainable land use.
Contact Now
Precise Aqua Lab
Our Products
- MaxDetect WSSV qPCR Detection Kit
- MaxDetect EHP qPCR Detection Kit
- MaxDetect IHHNV qPCR Detection Kit
- MaxDetect AHPND/EMS qPCR Detection Kit
- MaxDetect TSV qPCR Detection Kit
- MaxDetect YHV qPCR Detection Kit
- MaxDetect IMNV qPCR Detection Kit
- MaxDetect NHPB qPCR Detection Kit
- MaxDetect DIV1 qPCR Detection Kit
- MaxDetect MBV qPCR Detection Kit
- MaxDetect HPV qPCR Detection Kit
- MaxDetect WSSV+EHP qPCR Detection Kit
- MaxDetect MBV+HPV qPCR Detection Kit
- MaxDetect KHV PCR Detection Kit
- MaxDetect SVCV PCR Detection Kit
- MaxDetect Megalocytivirus PCR Detection Kit
- MaxDetect RSIV PCR Detection Kit
- MaxDetect VNN PCR Detection Kit
- MaxDetect EUS PCR Detection Kit
- MaxDetect EHNV PCR Detection Kit
-
MaxDetect Streptococcus agalactiae /
iniae PCR Detection Kit - MaxDetect ERD PCR Detection Kit
- MaxDetect TiLV PCR Detection Kit
- MaxDetect ISKNV PCR Detection Kit
- MaxDetect WSSV PCR Detection Kit
- MaxDetect WSSV Nested PCR Detection Kit
- MaxDetect EHP Nested PCR Detection Kit
- MaxDetect IHHNV PCR Detection Kit
- MaxDetect AHPND/EMS PCR Detection Kit
- MaxDetect YHV PCR Detection Kit
- MaxDetect IMNV nested PCR Detection Kit
- MaxDetect NHPB PCR Detection Kit
- MaxDetect DIV1 Nested PCR Detection Kit
- MaxDetect MBV PCR Detection Kit
- MaxDetect HPV PCR Detection Kit
Precise Aqua Lab
Our Gallery
Address Details
- Phone: +91 97891 01662
- Email: preciseaqualab@gmail.com
- Address: No.64, First Floor, ECR Road, Perunthuravu Village, Chengalpattu District - 603305, Tamilnadu, India